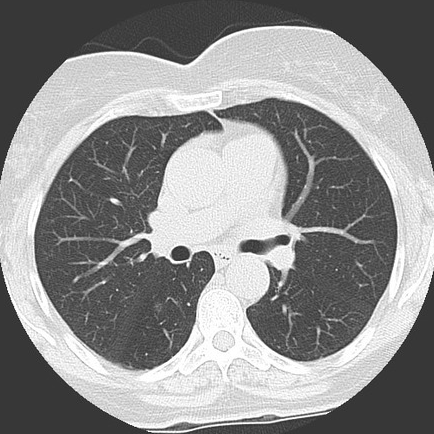

이슈있소
폐암의 씨앗, 간유리음영 폐결절 본문
건강검진 시즌이 돌아왔다. 국가건강검진 항목에는 신체계측, 시력 및 청력검사, 혈압측정, 흉부 X-ray 검사, 혈액검사, 요검사, 구강검사 등이 포함된다. 그런데 최근에는 MRI나 CT 등 비급여 항목들을 검진에 무료로 포함시켜 차별화를 두는 기관들도 많다. 건강검진에서 흉부 CT 검사가 보편화되면서 발견하기 쉬워진 질환이 있다. 바로 폐암의 씨앗이라 불리는 ‘간유리음영 폐결절’이다. 다소 생소할 수 있는 간유리음영에 대해 자세히 알아봤다.
1. 간유리음영 폐결절이란?
결절을 보기 위해서는 폐실질을 보게 되는데, 결절은 CT 검사 상 하얗게 보입니다. 간유리음영이라고 하는 것은 정상적인 폐 구조물의 음영이 비쳐 보일 정도로 약간만 음영이 증가한 결절을 말합니다. 단단하지 않은 성분으로 이루어져 있기 때문입니다. 정상조직의 음영이 다 보이지 않을 정도로 음영이 증가한 결절은 고형결절이라고 부릅니다.
2. 간유리음영 폐결절 진단을 받았는데, 무슨 의미인가요?
간유리음영은 국소적인 폐섬유화, 폐포세포의 이상증식 혹은 작은 국소적 염증 등 여러 질환에서 보일 수 있는 비특이적 소견입니다. 폐포세포 이상증식 같은 경우는 폐 암종으로 진행할 수 있습니다.
3. CT 검사로 간유리음영이 양성인지 악성인지 알 수 있나요?
간유리음영으로 보이는 폐결절은 반드시 추적검사를 해야 합니다. 그 자체로 양성인지 악성인지 알 수 없기 때문입니다. 몇 개월 간격으로 검사를 해서 크기의 변화나 음영의 정도에 차이가 있는지를 확인하게 됩니다. 결절은 최대 2년까지 추적검사를 해서 결론을 내리는데, 아주 드물게는 2년 이상 초과한 시기에 암으로 진단되기도 합니다. 따라서 간유리음영 진단을 받았다면 추적검사를 지속적으로 받는 게 최선입니다.
4. 폐결절이 폐암일 가능성은 얼마나 되나요?
폐결절, 즉 폐에서 발견되는 조그만한 혹은 장차 암의 가능성을 시사하는 소견이 될 수 있습니다. 보고에 따르면 흡연자의 폐결절은 약 50%까지 암의 가능성이 있습니다. 비흡연자에서도 폐결절의 암 가능성은 위험인자에 따라 많게는 30%까지 보고되고 있습니다. 하지만 개개인에 따라 가능성은 다르기 때문에 폐결절의 크기, 형태, 위치, 개수 등을 종합하여 암 진행 위험도를 예측하게 됩니다.
5. 결절의 형태에 따라 위험도가 다른가요?
결절의 형태가 간유리음영성 결절인 경우에는 고형결절에 비해 악성의 빈도가 높습니다. 따라서 3개월 후에 바로 추적 검사를 하는 것이 좋습니다.
'트렌딕, 앎을 선도하다' 카테고리의 다른 글
| 저녁형 인간 & 제2형 당뇨병 (0) | 2023.09.16 |
|---|---|
| 가을철 야외활동 등산 시 발목염좌 & 무릎 반월상연골판 부상 주의 (0) | 2023.09.15 |
| 햄스트링 근육 늘려주는 스트레칭 운동 동작 자세 방법 3가지 (0) | 2023.09.15 |
| 건강에 안 좋은 식사 후 행동 습관 4가지 (0) | 2023.09.15 |
| 스마일라식 인증 병원, 주의사항 & 클리어라식 스마트라식 차이점 (0) | 2023.09.15 |